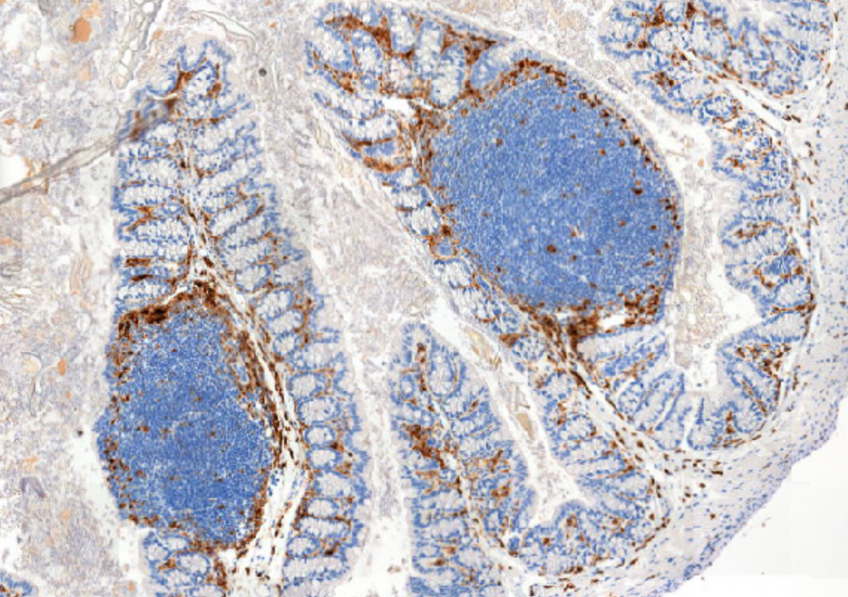
Le microbiote : le secret pour prédire votre tolérance aux additifs alimentaires

Le microbiote intestinal, cette colonie de bactéries qui réside dans nos intestins, joue un rôle crucial dans notre bien-être global. Désormais, des études révèlent son potentiel pour prédire notre sensibilité aux additifs alimentaires, ces substances omniprésentes dans notre alimentation industrielle.
**Les émulsifiants : des perturbateurs insoupçonnés**
Les émulsifiants, utilisés pour améliorer la texture et la conservation des aliments, se retrouvent dans tout, des pains de mie aux crèmes glacées. Cependant, des recherches récentes ont soulevé des inquiétudes quant à leur impact sur la santé, notamment sur l’intestin.
**Le microbiome, un révélateur de tolérance**
Une étude de l’Institut national de la recherche agronomique (INRA) a démontré que la composition du microbiote peut prédire la tolérance ou l’intolérance d’un individu aux émulsifiants. Chez les personnes présentant une intolérance, les bactéries bénéfiques étaient perturbées, laissant le champ libre aux espèces indésirables.
**Un outil de personnalisation de l’alimentation**
Ces découvertes ouvrent la voie à de nouvelles stratégies de personnalisation de l’alimentation. En analysant le microbiote d’un individu, les chercheurs pourraient déterminer les additifs alimentaires qu’il tolère ou non.
« La compréhension de ce lien entre le microbiote et la tolérance aux additifs alimentaires nous permettra de développer des recommandations alimentaires personnalisées », déclare le Dr Marie-Claire Reynier, chercheuse à l’INRA.
**Impact sur la santé intestinale**
Les émulsifiants peuvent altérer l’intégrité de la barrière intestinale, facilitant ainsi le passage de substances nocives dans le sang. « Cela pourrait avoir des conséquences sur la santé intestinale et systémique », avertit le Dr Reynier.
**Perspectives d’avenir**
Les recherches sur le lien entre le microbiote et les additifs alimentaires sont encore à leurs débuts, mais les implications potentielles sont considérables. Elles pourraient conduire à des stratégies nutritionnelles ciblées, à des aliments plus sains et à une meilleure santé globale.
**En résumé**
Le microbiote intestinal joue un rôle clé dans la tolérance aux additifs alimentaires. En analysant la composition du microbiote, les chercheurs peuvent prédire la sensibilité d’un individu à ces substances. Ces découvertes ouvrent la voie à des recommandations alimentaires personnalisées et à une meilleure compréhension de l’impact des additifs sur la santé intestinale.
**Mots-clés :** Microbiote, additifs alimentaires, émulsifiants, tolérance alimentaire, santé intestinale
